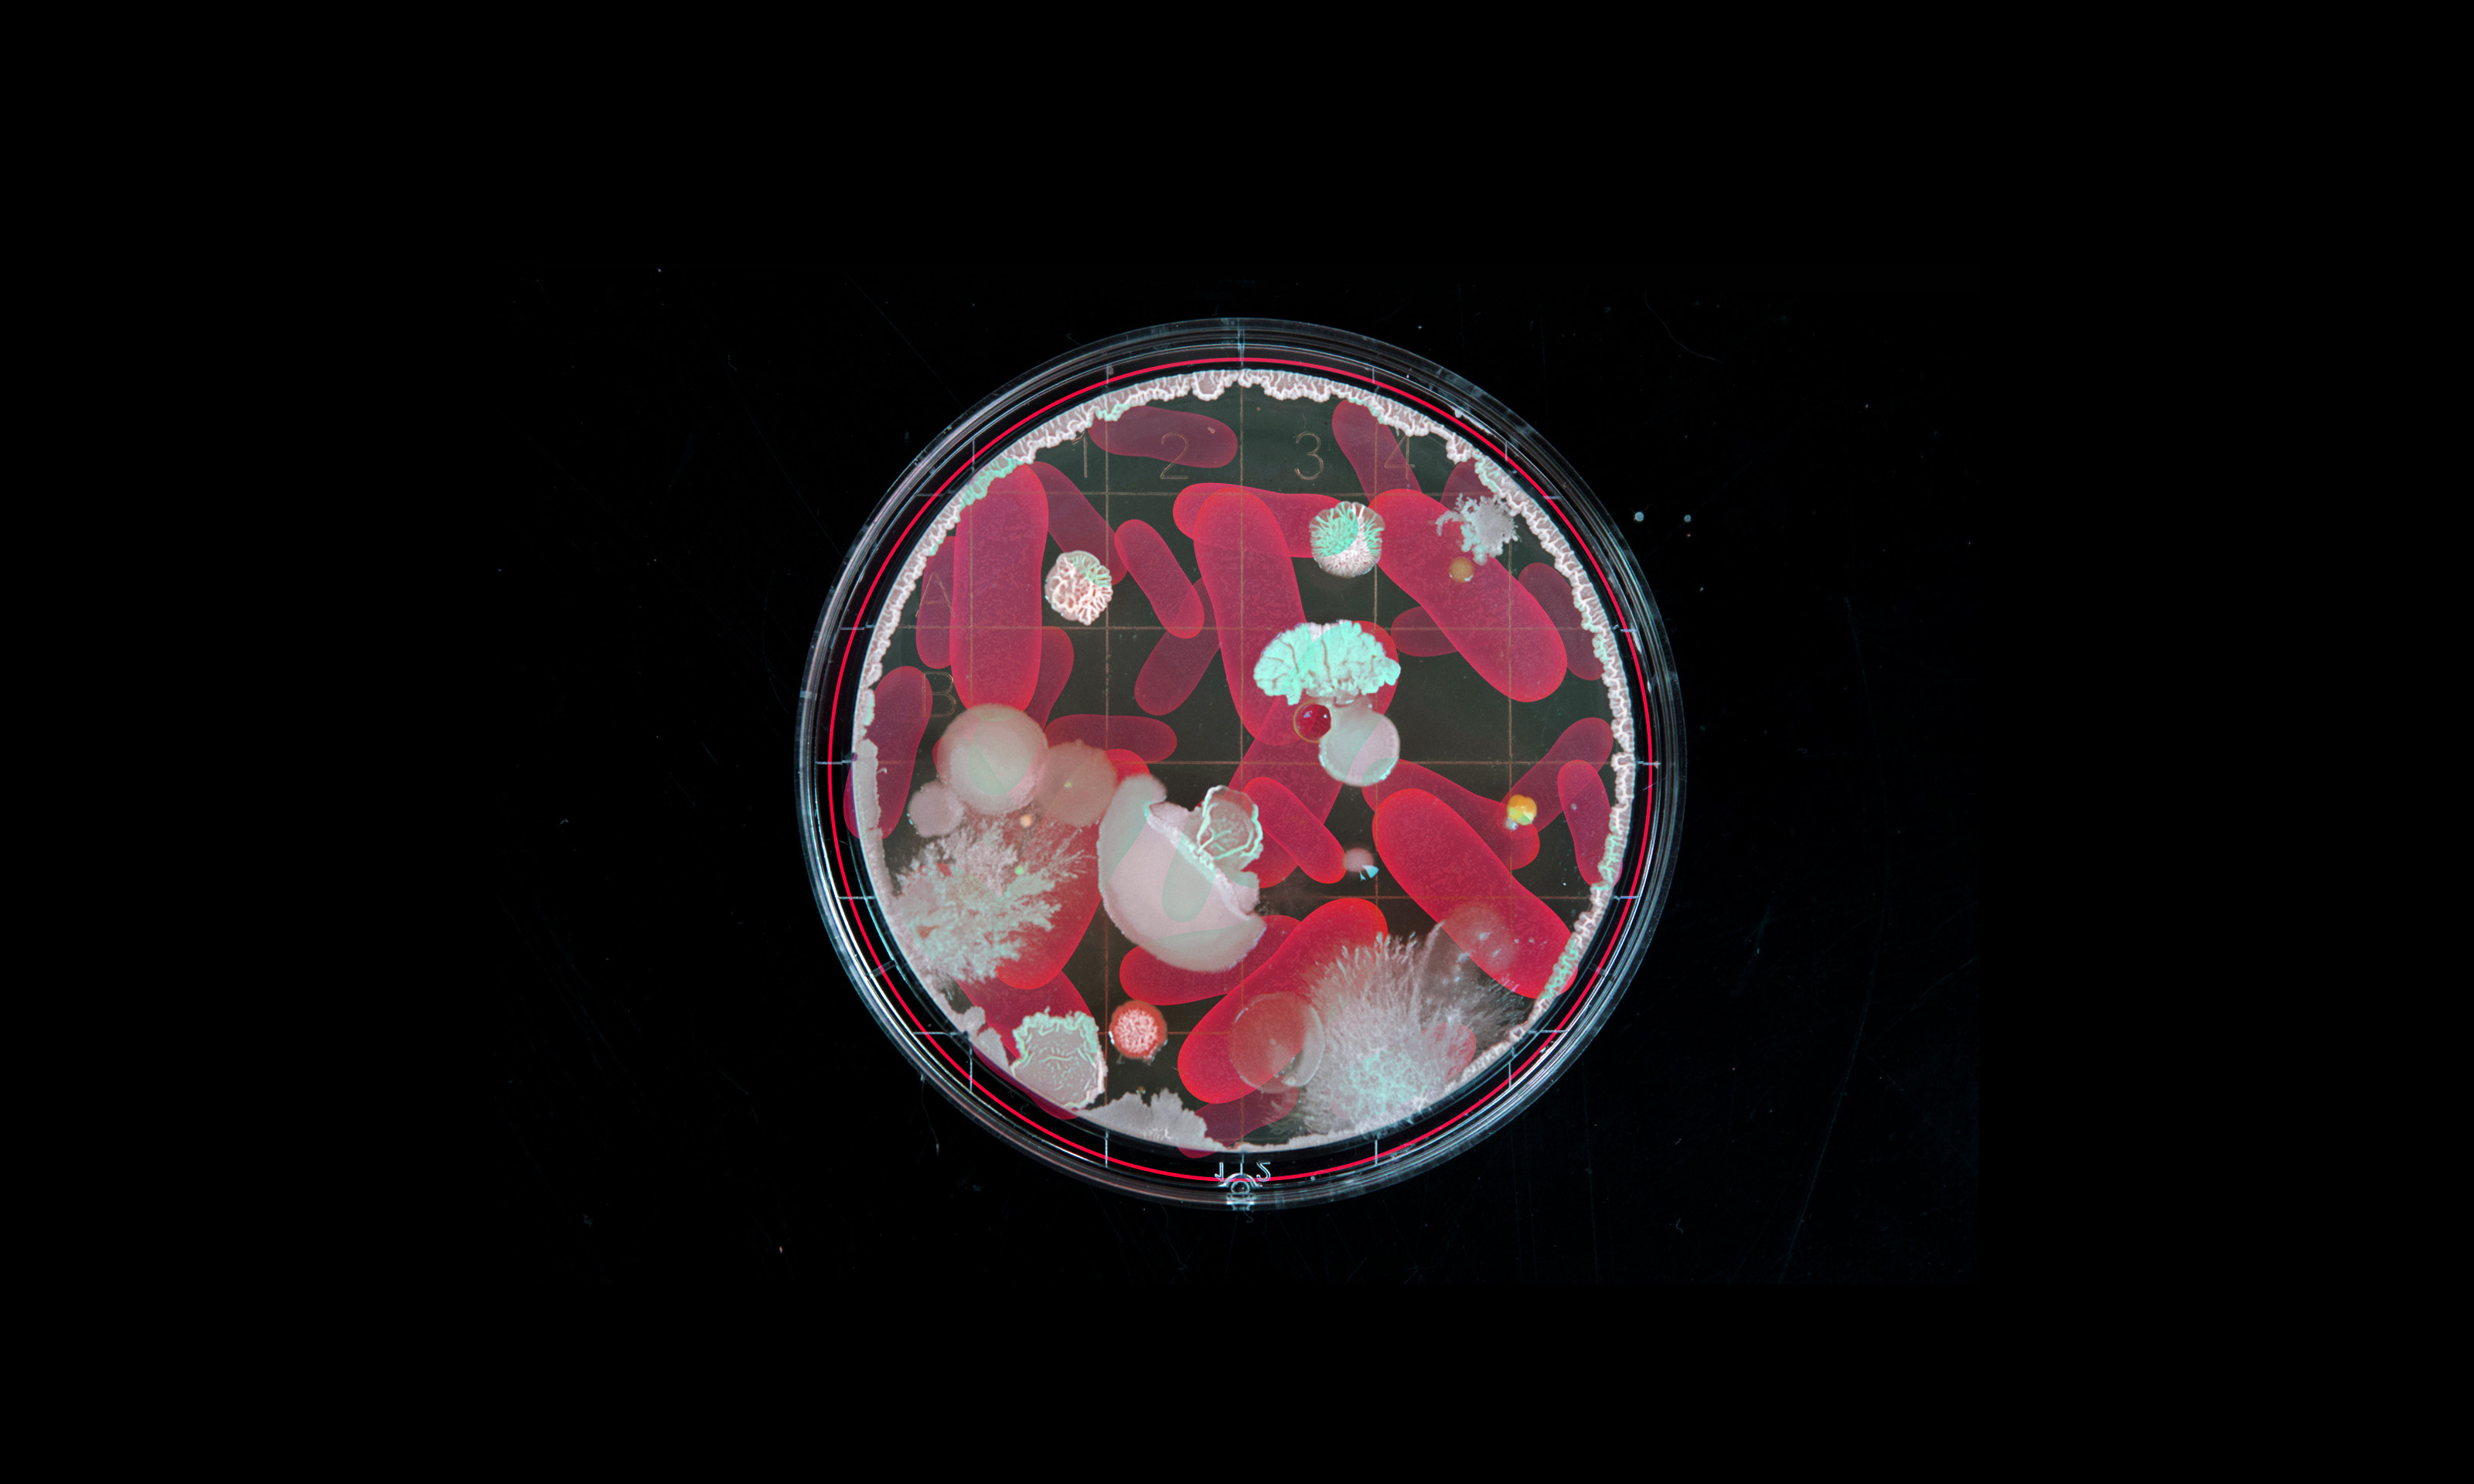

Insulin grown in lettuce can be taken orally
New synthetic insulin harvested from lettuce plants can be made cheaply, taken orally, and transported at room temperature.
Cancer med appears to prevent brain aneurysms
Japanese researchers have discovered that the cancer drug sunitinib can prevent the formation of brain aneurysms in mice.
“Nature’s own Ozempic” or berberine is all over social media
Does berberine work as well as Ozempic to help people lose weight? Social media seems to think so, but it’s not likely.
Rebecca Roubin and Nial Wheate and Tina Hinton